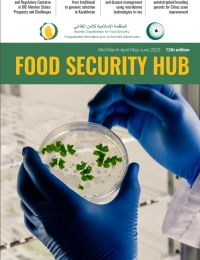
'FOOD SECURITY HUB' № 12

Islamic Organisation for Food Security
The strategic mission of the IOFS is to ensure sustainable food security in Member States
IOFS STRATEGIC PROGRAMMES
IOFS Member States
République du Kazakhstan
- Initiated the creation of IOFS
- Hosting State
Member since 2013 (Ratified the IOFS Statute in 2014)
République du Niger
Member since 2013 (Ratified the IOFS Statute in 2015)
Burkina Faso
Member since 2013 (Ratified the IOFS Statute in 2016)
République de Palestine
Member since 2013 (Ratified the IOFS Statute in 2016)
État du Koweït
Member since 2013 (Ratified the IOFS Statute in 2016)
Afghanistan
Member since 2013 (Ratified the IOFS Statute in 2020)
République de Gambie
Member since 2013 (Ratified the IOFS Statute in 2016)
République de Turquie
Member since 2013 (Ratified the IOFS Statute in 2020)
République populaire du Bangladesh
Member since 2016 (Ratified the IOFS Statute in 2017)
République islamique de Mauritanie
Member since 2013 (Ratified the IOFS Statute in 2020)
Union des Comores
Member since 2013
République de Djibouti
Member since 2013
République de Guinée
Member since 2013
République de Guinée-Bissau
Member since 2013
République islamique d’Iran
Member since 2013
République islamique de Mauritanie
Member since 2013
République de Sierra Leone
Member since 2013
Federal Republic of Somalia
Member since 2013
République du Soudan
Member since 2013
République du Suriname
Member since 2013
République d'Ouganda
Member since 2013
État de Libye
Member since 2014 (Ratified the IOFS Statute in 2021)
État des Emirats Arabes Unis
Member since 2015 (Ratified the IOFS Statute in 2018)
Royaume d’Arabie saoudite
Member since 2015 (Ratified the IOFS Statute in 2018)
République du Bénin
Member since 2015
État du Qatar
Member since 2016 (Ratified the IOFS Statute in 2017)
République Arabe d'Egypte
Member since 2016 (Ratified the IOFS Statute in 2018)
République du Tadjikistan
Member since 2016 (Ratified the IOFS Statute in 2021)
République du Cameroun
Member since 2015 (Ratified the IOFS Statute in 2022)
République de Côte d’Ivoire
Member since 2016
République du Mozambique
Member since 2016
République du Sénégal
Member since 2017
République islamique du Pakistan
Member since 2019 (Ratified the IOFS Statute in 2020)
République fédérale du Nigeria
Member since 2019
Royaume du Maroc
Member since 2021
République tunisienne
Member since 2021
République du Tchad
Member since 2022
The Republic of Gabon
Member since 2023
Hashemite Kingdom of Jordan
Member since 2023
The Republic of Yemen
Member since 2023
Republic of Iraq
Member since 2023
République d'Azerbaïdjan
Member since 2026
République d'Ouzbékistan
Member since 2026
All countries
EVENTS
15 October 2024
Strengthening Basmati Rice Production
07 October 2024
Hands-on Capacity-Building Workshop focused on High-yield and Climate-resilient Rice Production
26 September 2024
Conference on "Smarter Agriculture, Brighter Futures: Implementing Intelligent Agriculture"
08 September 2024
IOFS-HBKU Webinar Series: Water Security - Innovative Strategies for Financing, Policy, and Governance
28 August 2024
Join Us for Training on Biochar Application for Sustainable Farming!
24 July 2024
Webinar on Alfalfa Production in Turkiye
16 July 2024
IOFS to Host Webinar Workshop on Water Governance and Integrated Water Management for Lake Chad Basin Countries
24 June 2024
Webinar on Utilizing the Potential of Biochar for Soil Improvement and Sustainable Farming
14 May 2024
Training Course on “Genetic Engineering and Genetically Modified Organisms"
07 May 2024
Workshop on the Estimation and Implementation of Food Losses and Waste Management
journal
 FOOD SECURITY HUB №22
FOOD SECURITY HUB №22
 FOOD SECURITY HUB №21
FOOD SECURITY HUB №21
 FOOD SECURITY HUB №20
FOOD SECURITY HUB №20
 FOOD SECURITY HUB №19
FOOD SECURITY HUB №19
 FOOD SECURITY HUB №18
FOOD SECURITY HUB №18
 Food Security Hub №17
Food Security Hub №17
 FOOD SECURITY HUB №16
FOOD SECURITY HUB №16
 FOOD SECURITY HUB №15
FOOD SECURITY HUB №15
 FOOD SECURITY HUB №14
FOOD SECURITY HUB №14
 'FOOD SECURITY HUB' № 13
'FOOD SECURITY HUB' № 13
 'FOOD SECURITY HUB' № 12
'FOOD SECURITY HUB' № 12
 'FOOD SECURITY HUB' №11
'FOOD SECURITY HUB' №11
 'FOOD SECURITY HUB' № 10
'FOOD SECURITY HUB' № 10
 'FOOD SECURITY HUB' № 9
'FOOD SECURITY HUB' № 9
 'FOOD SECURITY HUB' № 8
'FOOD SECURITY HUB' № 8
 'FOOD SECURITY HUB' № 7
'FOOD SECURITY HUB' № 7
 'FOOD SECURITY HUB' № 6
'FOOD SECURITY HUB' № 6
 'FOOD SECURITY HUB' № 5
'FOOD SECURITY HUB' № 5
 'FOOD SECURITY HUB' № 4
'FOOD SECURITY HUB' № 4
 'FOOD SECURITY HUB' № 3
'FOOD SECURITY HUB' № 3
 'FOOD SECURITY HUB' № 2
'FOOD SECURITY HUB' № 2
 'FOOD SECURITY HUB' № 1
'FOOD SECURITY HUB' № 1